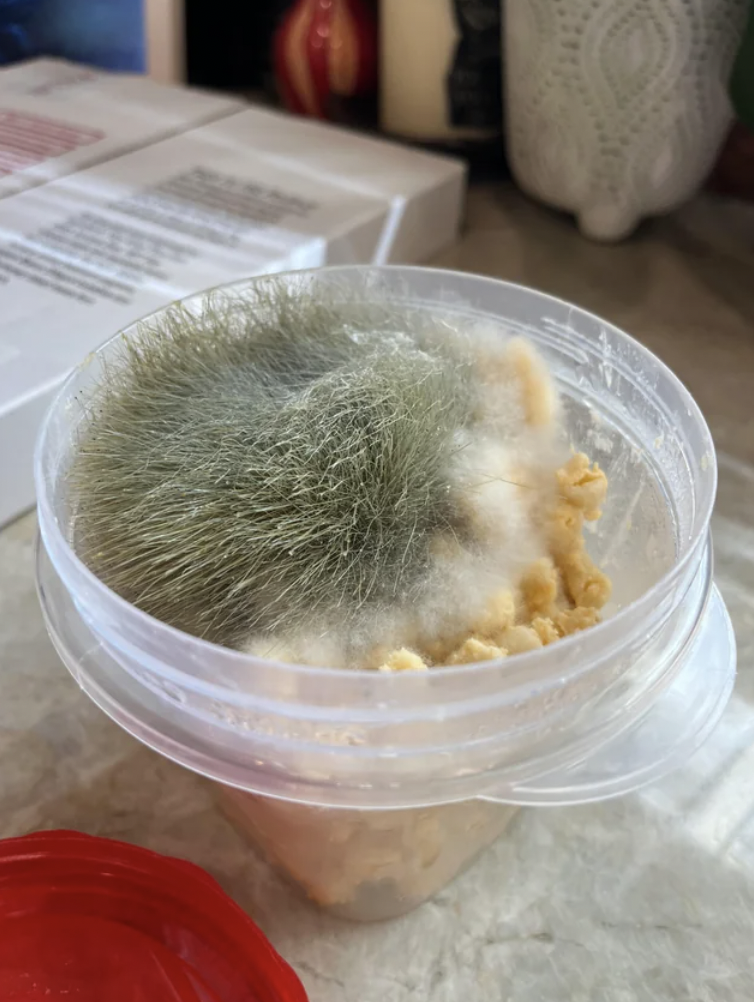

21 случай, когда плесень одержала полную победу
Плесень — не просто неприятная, но и опасная штука. Хотя выглядит она довольно мерзко, в ней есть что-то завораживающее и её интересно разглядывать. У каждого из нас бывали случаи, когда мы сталкивались с «монстрами из плесени» — будь то забытые остатки еды или отсыревшие вещи. Увы, плесень рано или поздно поглощает всё.

1. «Забыла, что оставила это остывать в духовке. Примерно три недели назад это был яблочный крамбл»

2. «Я ведь не зря беспокоюсь из-за этого, да?»

3. «Наконец-то я выбросила свой свадебный торт шестимесячной давности»

4. «Бывший апельсин»

5. «Странные пушистые штуки растут из макарон с сыром двухнедельной давности!»

6. «Что делать со сковородкой, выбрасывать?»

7. «Моя духовка»

8. «Этот заплесневелый персик выглядит так, будто у него есть глаз»

9. «Вишни, забытые на месяц»

10. «Груши, забытые с прошлого года»

11. «Нашел это на работе, выглядит интересно»

12. «Результат сырости»

13. «Не знаю, что живет в моем мусоре»

14. «Плесень справилась с хэллоуинской тыквой примерно за неделю»

15. «Проклятые спагетти»

16. «Заплесневевшая надпись «Уксус» на бутылке»

17. «Боксёрский манекен после нескольких месяцев на улице»

18. «Мой волосатый нож!»

19. «Что происходит, если не держать гипс сухим. Да, это плесень»

20. «Тушёная свинина, которая пролежала в холодильнике слишком долго»

21. «Вяленая говядина, которая сдалась под напором плесени»

1. «Забыла, что оставила это остывать в духовке. Примерно три недели назад это был яблочный крамбл»

2. «Я ведь не зря беспокоюсь из-за этого, да?»

3. «Наконец-то я выбросила свой свадебный торт шестимесячной давности»

4. «Бывший апельсин»

5. «Странные пушистые штуки растут из макарон с сыром двухнедельной давности!»
6. «Что делать со сковородкой, выбрасывать?»

7. «Моя духовка»

8. «Этот заплесневелый персик выглядит так, будто у него есть глаз»

9. «Вишни, забытые на месяц»

10. «Груши, забытые с прошлого года»

11. «Нашел это на работе, выглядит интересно»

12. «Результат сырости»

13. «Не знаю, что живет в моем мусоре»

14. «Плесень справилась с хэллоуинской тыквой примерно за неделю»

15. «Проклятые спагетти»

16. «Заплесневевшая надпись «Уксус» на бутылке»

17. «Боксёрский манекен после нескольких месяцев на улице»

18. «Мой волосатый нож!»

19. «Что происходит, если не держать гипс сухим. Да, это плесень»

20. «Тушёная свинина, которая пролежала в холодильнике слишком долго»

21. «Вяленая говядина, которая сдалась под напором плесени»
Только зарегистрированные и авторизованные пользователи могут оставлять комментарии.
0
Красота!
- ↓

